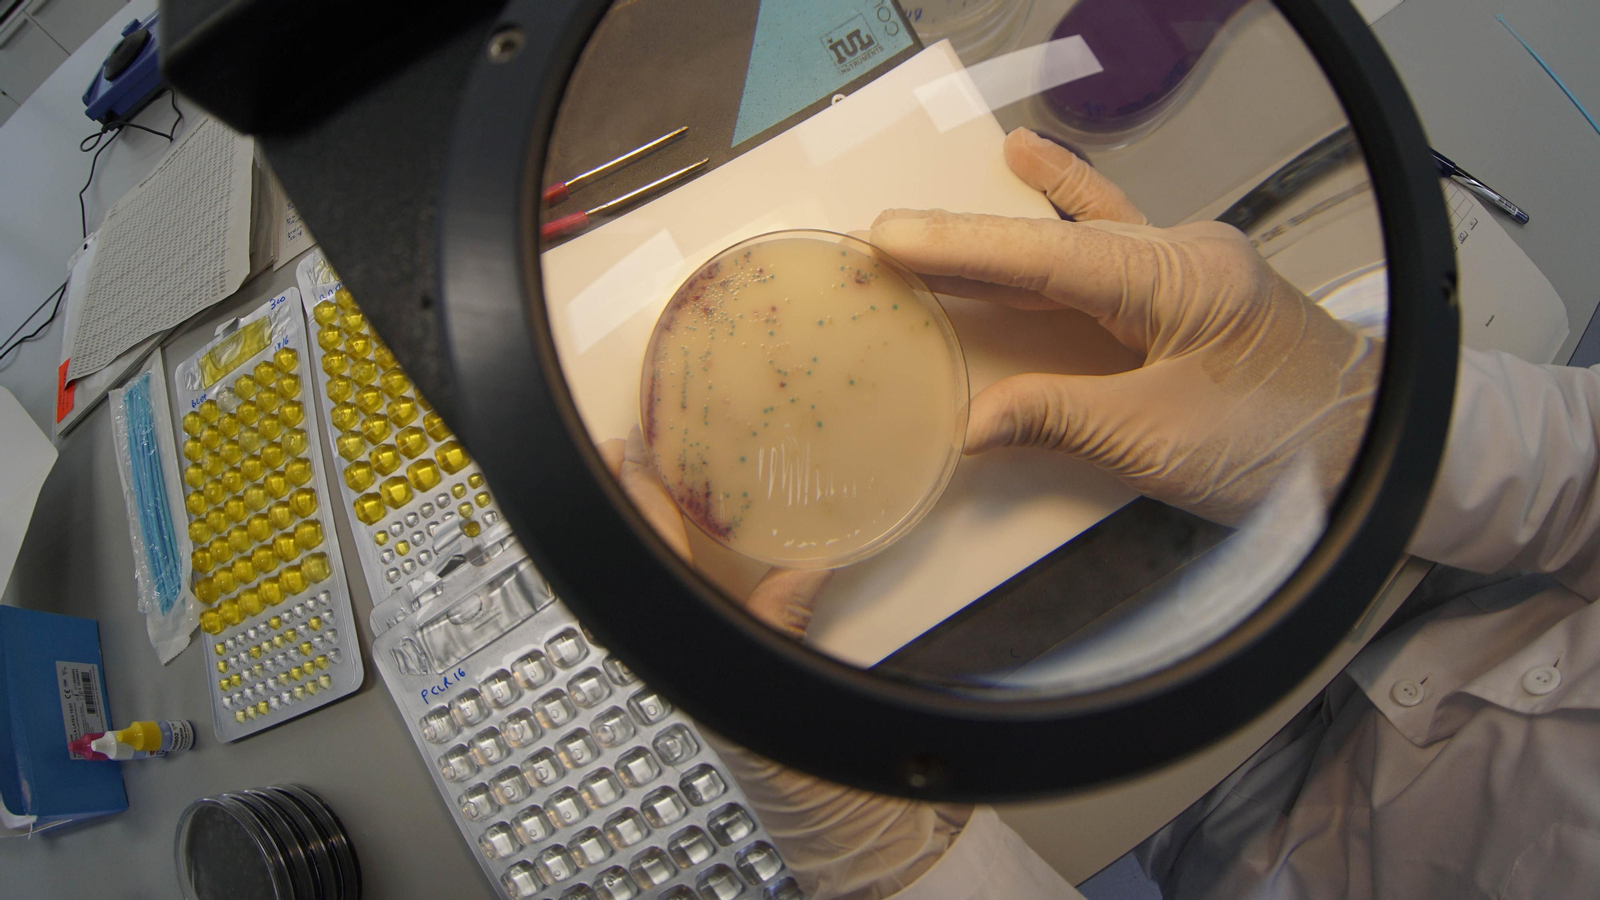
Unidad de microbiología del laboratorio de Emasesa, donde se detecta la presencia del Covid-19 en las aguas residuales.

Las cinco fases para hallar Covid en las aguas residuales de Emasesa
Medidas de seguridad
El rastreo del coronavirus se lleva a cabo en el nuevo laboratorio que la empresa posee en la estación del Carambolo
El proceso concluye con el análisis del RNA de la bacteria
Así investiga Emasesa si hay Covid-19 en Sevilla
Un antiguo depósito de agua convertido en uno de los laboratorios más avanzados de Europa. Emasesa rastrea las aguas residuales para detectar restos del Covid-19 en unas de las instalaciones en las que se ha aplicado la economía circular, esto es, son resultado de aprovechar infraestructuras antiguas a las que se les dota de un uso distinto al original.
El laboratorio se encuentra en la estación del Carambolo, en la Cuesta del Caracol. Allí nos reciben Jaime Palop, consejero delegado de Emasesa; José Antonio González, jefe de la División de Calidad del Agua; y Lucila Cuberos, jefa del Departamento de Control de Calidad.
El suelo que ahora pisan técnicos y biólogos estaba en su día lleno de agua. Hasta 80.000 metros cúbicos cabían aquí. Las numerosas filtraciones provocaron su sustitución por otro y que su estructura básica se aprovechara para este laboratorio, donde la empresa metropolitana ha invertido cuatro millones de euros, lo que supone un ahorro de millón y medio respecto a uno de nueva planta.

En este inmenso espacio se han centralizado todos los laboratorios de los que disponía Emasesa. Este servicio se divide en tres grandes áreas. La primera de ella es la físico-química, que, como su nombre indica, se encarga de controlar la calidad química de las aguas potables y residuales, que permanecen en todo momento separadas para que no se produzca una "contaminación cruzada", como explica José Antonio González.
Al entrar en sus diferentes dependencias llaman la atención dos aspectos. Por un lado, el escrupuloso seguimiento de las medidas de seguridad e higiene contra el coronavirus; y por otro, el distanciamiento de los profesionales que aquí trabajan. "Se optó por esta separación antes de la pandemia, pues, debido a las sustancias que se analizan, debemos evitar cualquier tipo de contagio entre los trabajadores", argumenta González.

En esta unidad se investigan los microplásticos y las sustancias emergentes, entendiéndose como tales los antibióticos y todo tipo de medicinas que se excretan. En ella, como en las otras dos, hay itinerarios establecidos frente al Covid-19. Dispone, en algunos de sus módulos, de aspiradores para emanar gases y de espacios denominados de "presión positiva" para evitar que entre aire de fuera. "Así no se incorporan partículas exteriores a la hora de analizar los nanogramos". Este concepto, habitual en la jerga científica, se refiere a una pequeñísima unidad de medida.
Conviene recordar, en este sentido, que Emasesa realiza durante el año 112.000 analíticas, lo que supone una media diaria de 310, las cuales, a su vez, se subdividen para los distintos estudios a los que se someten, hasta llegar a esa milésima parte. Dicha operación permite localizar los microcontaminantes inorgánicos, procedentes de metales pesados, algunos de los cuales, como el plomo o el níquel resultan muy tóxicos y su nivel de aparición en las aguas se encuentran legislados, al afectar a la salud pública. Pueden proceder de tuberías de plomo muy antiguas de las que se desprende este material.

La segunda unidad es la de ecología acuática, referida a la calidad de las aguas en origen; y por último, donde se rastrea el Covid-19, es la de microbiología. En este departamento, a diferencia del físico-químico, hay salas de presión negativa, que no dejan salir el aire, al tratarse de zonas de máxima seguridad, donde se analizan bacterias como la legionella.
Aquí toma ya la palabra Lucila Coberos, jefa del Departamento de Control de Calidad, que detalla el proceso que se sigue con el agua residual hasta detectar algún virus en ellas. Las muestras llegan aquí después de haber sido tomadas en las entradas de las depuradoras, en los puntos nodales y en otros de la capital y los municipios sevillanos a los que abastece la empresa metropolitana. Todos se encuentran en la red de saneamiento.

Una vez extraídas, al llegar al laboratorio del Carambolo se codifican para su trazabilidad. Entre los datos que se le aportan están la fecha de la toma y la procedencia. Con la muestra identificada se pasa a la tercera fase, la de concentración, para lo que se vierte un floculante (aglutinador de sustancias) y se centrifuga con la intención de reducirla de volumen. Se trata de ir concretando la bacteria o virus que el agua contenga en un vial de 250 mililitros.
En dicho instrumental, por tanto, se deposita el material genético, el RNA (el ácido ribunocleico) presente en los virus. Para su estudio es necesario pasar a la cuarta fase, la amplificación, donde se aumenta esa carga genética para que a través de los reactivos, que poseen ondas fluorescentes, un equipo tecnológico especializado pueda leerla en la quinta y última fase donde se comprueba ese RNA y se determina el tipo de bacteria al que corresponde.

Así se viene haciendo en este laboratorio desde que empezó a funcionar a finales de 2019. Su inauguración oficial no se pudo llevar a cabo por el estado de alarma, pero sí ha servido para constatar la utilidad de dichos análisis a la hora de detectar restos de coronavirus en las aguas residuales. Gracias a las muestras congeladas previas al 11 de marzo, se ha localizado la presencia del Covid-19 en cuatro depuradoras. Unos positivos que fueron aumentando conforme evolucionaba la pandemia. Desde mediados de mayo, eso sí, todas las pruebas realizadas han dado negativo.
Este proceso es el que le ha servido al Ayuntamiento de Sevilla para proponer a la Junta de Andalucía un acuerdo de colaboración mediante el cual el análisis de las muestras de aguas residuales sirva para adelantarse a un posible brote de coronavirus y, a partir de ahí, en coordinación con la Consejería de Salud establecer las medidas sanitarias y de seguridad pertinentes.
También te puede interesar
Lo último








